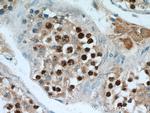
SPAG5 Antibody in Immunohistochemistry (Paraffin) (IHC (P))
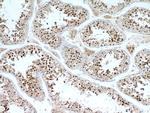
SPAG5 Antibody in Immunohistochemistry (Paraffin) (IHC (P))

Search
Proteintech
SPAG5 Polyclonal Antibody
{{$productOrderCtrl.translations['antibody.pdp.commerceCard.promotion.promotions']}}
{{$productOrderCtrl.translations['antibody.pdp.commerceCard.promotion.viewpromo']}}
{{$productOrderCtrl.translations['antibody.pdp.commerceCard.promotion.promocode']}}: {{promo.promoCode}} {{promo.promoTitle}} {{promo.promoDescription}}. {{$productOrderCtrl.translations['antibody.pdp.commerceCard.promotion.learnmore']}}
产品信息
14726-1-AP
种属反应
已发表种属
宿主/亚型
分类
类型
抗原
偶联物
形式
浓度
规格
纯化类型
保存液
内含物
保存条件
运输条件
产品详细信息
This antibody is specific to SPAG5.
Immunogen sequence: TVENLTAKL ASTIADNQEQ DLEKTRQYSQ KLGLLTEQLQ SLTLFLQTKL KEKTEQETLL LSTACPPTQE HPLPNDRTFL GSILTAVADE EPESTPVPLL GSDKSAFTRV ASMVSLQPAE TPGMEESLAE MSIMTTELQS LCSLLQESKE EAIRTLQRKI CELQARLQAQ EEQHQEVQKA KEADIEKLNQ ALCLRYKNEK ELQEVIQQQN EKILEQIDKS GELISLREEV THLTRSLRRA ETETKVLQEA LAGQLDSNCQ PMATNWIQEK VWLSQEVDKL RVMFLEMKNE KEKLMIKFQS HRNILEENLR RSDKELEKLD DIVQHIYKTL LSIPEVVRGC KELQGLLEFL S (844-1193 aa encoded by BC000322)
靶标信息
SPAG5 (sperm associated antigen 5), also known as MAP126, hMAP126, DEEPEST or Astrin, is a 1,193 amino acid protein that is expressed at high levels in testis and at lower levels in liver, placenta, pancreas, colon and thymus. Localized specifically to spindle poles during prophase and throughout the spindle during metaphase and anaphase, SPAG5 is essential for proper spindle formation and is thought to be involved in the dynamic and functional regulation of mitotic spindles. Additionally, SPAG5 plays a role in sister chromatid cohesion and subsequent chromatid separation and, via its association with chromatids, is an important regulator of chromosome integrity. SPAG5 has a long stalk and a globular head domain through which if forms a homodimer that is characterized by aster-like structures. Upon DNA damage, SPAG5 may be phosphorylated by ATR or ATM.
仅用于科研。不用于诊断过程。未经明确授权不得转售。
生物信息学
蛋白别名: Astrin; coiled-coil protein; Deepest; MAP126; Mastrin; microtubule-associated protein; mitotic spindle associated protein p126; mitotic spindle coiled-coil related protein; Mitotic spindle-associated protein p126; Sperm-associated antigen 5; unnamed protein product
基因别名: AI874642; D11Bhm180e; DEEPEST; hMAP126; MAP126; Mastrin; S17; SPAG5
UniProt ID: (Human) Q96R06, (Mouse) Q7TME2
Entrez Gene ID: (Human) 10615, (Mouse) 54141